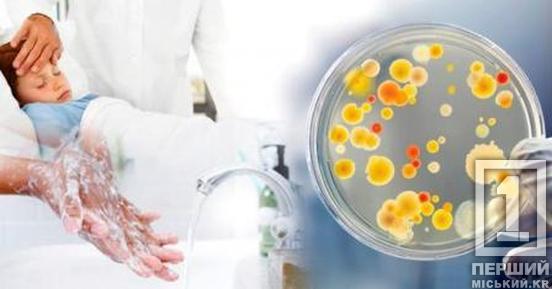

Длительные отключения света в Украине: как не заработать себе острую кишечную инфекцию
Криворожский РВ ДОЦКПХ продолжает мониторить ситуацию с острыми кишечными инфекциями в городе. Основным фактором, из-за которого страдают люди, остается мясо.

Детей до 17 лет среди больных насчитали 69,5%. Среди продуктов, способствующих передаче ОКИ, распределение по «влиянию» выглядит так:
- 38,5% – мясные изделия.
- 23,6% – молочные продукты.
- 8,8% – яйца.
«В Кривом Роге в 2025 году по сравнению с прошлым годом наблюдалось снижение заболеваемости острыми кишечными инфекциями на 14,4% (1059 случаев против 1257). В 2026 году заболеваемость выросла на 4 случая с 1 по 7 января и снизилась на 11 случаев с 8 по 14 января», - отмечают специалисты.
Как уберечься от неприятностей в период блэкаутов:
- Для питья, приготовления пищи, мытья фруктов и овощей – исключительно кипяченая или фасованная бутилированная вода.
- Не употребляйте продукты, простоявшие без охлаждения 4+ часа.
- Готовьте небольшие количества, на один прием.
- Отдавайте предпочтение продуктам длительного хранения.
- Мясо, птица, рыба и яйца должны быть хорошо прожарены или проварены.
- Не покупайте готовые блюда и все, что быстро теряет нормальные качества, в местах несанкционированной торговли.
- Соблюдайте личную гигиену.
«При поносе и тошноте обязательно обратитесь к врачу, особенно если симптомы выражены, длятся более одного-двух дней или сопровождаются высокой температурой. Не занимайтесь самолечением», - акцентируют врачи.
Напомним, ранее мы писали о том, что в украинской энергетике действует режим чрезвычайной ситуации из-за атак оккупантов.

- 23,6% – молочные продукты.
- 8,8% – яйца.
- Не употребляйте продукты, простоявшие без охлаждения 4+ часа.
- Готовьте небольшие количества, на один прием.
- Отдавайте предпочтение продуктам длительного хранения.
- Мясо, птица, рыба и яйца должны быть хорошо прожарены или проварены.
- Не покупайте готовые блюда и все, что быстро теряет нормальные качества, в местах несанкционированной торговли.
- Соблюдайте личную гигиену. «При поносе и тошноте обязательно обратитесь к врачу, особенно если симптомы выражены, длятся более одного-двух дней или сопровождаются высокой температурой. Не занимайтесь самолечением», - акцентируют врачи. Напомним, ранее мы писали о том, что в украинской энергетике действует режим чрезвычайной ситуации из-за атак оккупантов.